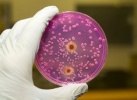
Сальмонеллёз.

06.07.2016
06.07.2016
Важность физического воспитания.
Норвежские, австралийские и американские врачи определили оптимальный продолжительность физических упражнений административных работников для укрепления их здоровья.
 01.07.2016
01.07.2016
Безопасность детских игрушек.
Как известно детские игрушки и игры имеют большое значение для умственного и психического развития детей. Однако учитывая, что при их производстве применяются различные материалы, которым придают тот или...
 14.06.2016
14.06.2016
Было проведено концертное выступление посвящённое «Всемирному дню доноров».
14 – июня 2016 года было проведено концертное выступление и акция молодёжи «Камолот» Республики Каракалпакстан посвящённое «Всемирному дню доноров» в большом зале Республиканского детского противотуберкулёзного...
 11.06.2016
11.06.2016
Проведён семинар - тренинг на тему «Профилактические мероприятия проводимые по пищевым отравлениям».
В 2016 году 10 – июня был проведен семинар – тренинг с медицинскими сотрудниками Центра государственного санитарно – эпидемиологического надзора Республики Каракалпакстан с участием заведующего...
16.05.2016
16.05.2016
Сальмонеллёз.
Сальмонеллез - инфекционная болезнь животных и человека. Заболевание относится к группе кишечных инфекций, вызываемоеразличными представителями бактерий рода сальмонелла.Основным источником...
 12.05.2016
12.05.2016
О постановлении, Кабинета Министров Республики Узбекистан «Об утверждении положений о порядке прохождения разрешительных процедур в системе санитарно-эпидемиологической службы Республики Узбекистан» за № 131 от 30 апреля 2016 года.
Данное постановление Кабинета Министров Республики Узбекистан принят в соответствии с Законами Республики Узбекистан «О санитарно-эпидемиологическом благополучии населения» и «О разрешительных процедурах...
 07.05.2016
07.05.2016
Актуальные вопросы иммунопрофилактики.
На семинаре была представлена обзорная информация:о подготовке к элиминации кори в республике,по внедрению бивалентной полиомиелитной вакцины,об организации и проведении экстренной...
 05.05.2016
05.05.2016
Актуальные вопросы паразитологии.
На семинаре были обсуждены актуальные и проблемные вопросы в области паразитологии по мероприятиям по КВТ, лейшманиозам, гельминтозам их профилактике, лабораторной диагностике (организованы...
 02.05.2016
02.05.2016
Актуальные вопросы профилактики внутрибольничных и гемоконтактных инфекций.
Организован семинар - совещание для специалистов отдела по контролю за лечебно - профилактическими учреждениями ЦГСЭН Р.Каракалпакстан, областей и г.Ташкента.
 29.04.2016
29.04.2016
Cостоялся республиканский семинар для заведующих эпидемиологическими отделами и бактериологическими лабораториями областных ЦГСЭН, Республики Каракалпакстан и г.Ташкента.
Семинар проводился перед началом подъема заболеваемости кишечными инфекциями, и основной задачей данного семинара было обсудить со всеми заинтересованными специалистами проведение необходимого комплекса...


 Форма обратной связи
Форма обратной связи Сайты Единой информационной сети
Медицинского портала Узбекистана
Сайты Единой информационной сети
Медицинского портала Узбекистана  Вопросы-ответы
Вопросы-ответы